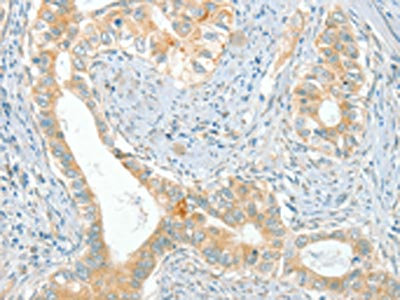

ACE Antibody
-
中文名稱:ACE兔多克隆抗體
-
貨號:CSB-PA271234
-
規格:¥1100
-
圖片:
-
The image on the left is immunohistochemistry of paraffin-embedded Human cervical cancer tissue using CSB-PA271234(ACE Antibody) at dilution 1/80, on the right is treated with synthetic peptide. (Original magnification: ×200)
-
The image on the left is immunohistochemistry of paraffin-embedded Human breast cancer tissue using CSB-PA271234(ACE Antibody) at dilution 1/80, on the right is treated with synthetic peptide. (Original magnification: ×200)
-
Gel: 10%SDS-PAGE, Lysate: 40 μg, Lane 1-3: Human ileum adenocarcinoma tissue, Human testis tissue, Human prostate tissue, Primary antibody: CSB-PA271234(ACE Antibody) at dilution 1/270, Secondary antibody: Goat anti rabbit IgG at 1/8000 dilution, Exposure time: 10 seconds
-
-
其他:
產品詳情
-
Uniprot No.:
-
基因名:
-
別名:ACE 1 antibody; ACE antibody; ACE T antibody; ACE_HUMAN antibody; ACE1 antibody; Angiotensin converting enzyme somatic isoform antibody; Angiotensin converting enzyme testis specific isoform antibody; Angiotensin I converting enzyme 1 antibody; Angiotensin I converting enzyme antibody; Angiotensin I converting enzyme peptidyl dipeptidase A 1 antibody; angiotensin I converting enzyme peptidyl-dipeptidase A 1 transcript antibody; Angiotensin-converting enzyme antibody; Carboxycathepsin antibody; CD 143 antibody; CD143 antibody; CD143 antigen antibody; DCP 1 antibody; DCP antibody; DCP1 antibody; Dipeptidyl carboxypeptidase 1 antibody; Dipeptidyl carboxypeptidase I antibody; Kininase II antibody; MGC26566 antibody; MVCD3 antibody; Peptidase P antibody; Peptidyl dipeptidase A antibody; soluble form antibody; Testicular ECA antibody
-
宿主:Rabbit
-
反應種屬:Human,Mouse,Rat
-
免疫原:Synthetic peptide of Human ACE
-
免疫原種屬:Homo sapiens (Human)
-
標記方式:Non-conjugated
-
抗體亞型:IgG
-
純化方式:Antigen affinity purification
-
濃度:It differs from different batches. Please contact us to confirm it.
-
保存緩沖液:-20°C, pH7.4 PBS, 0.05% NaN3, 40% Glycerol
-
產品提供形式:Liquid
-
應用范圍:ELISA,WB,IHC
-
推薦稀釋比:
Application Recommended Dilution ELISA 1:1000-1:2000 WB 1:200-1:1000 IHC 1:50-1:200 -
Protocols:
-
儲存條件:Upon receipt, store at -20°C or -80°C. Avoid repeated freeze.
-
貨期:Basically, we can dispatch the products out in 1-3 working days after receiving your orders. Delivery time maybe differs from different purchasing way or location, please kindly consult your local distributors for specific delivery time.
-
用途:For Research Use Only. Not for use in diagnostic or therapeutic procedures.
相關產品
靶點詳情
-
功能:Converts angiotensin I to angiotensin II by release of the terminal His-Leu, this results in an increase of the vasoconstrictor activity of angiotensin. Also able to inactivate bradykinin, a potent vasodilator. Has also a glycosidase activity which releases GPI-anchored proteins from the membrane by cleaving the mannose linkage in the GPI moiety.
-
基因功能參考文獻:
- The study suggests that the ACE I/D polymorphism may contribute to mechanisms and intensity of DNA damage in hypertensive and normotensive individuals. PMID: 30480916
- study found a significant association between the ACE insertion/deletion polymorphism and Kawasaki disease risk - meta-analysis PMID: 29937869
- ACE gene I/D polymorphism was not associated with the risk of chronic obstructive pulmonary disease. PMID: 29716409
- aerobic exercise training differentially affects the ACE C- and N-domain activities, and the N-domain activity is dependent on ACE polymorphism. PMID: 29629833
- A significant difference was found between the patients with familial Mediterranean fever (FMF)-related amyloidosis and the control group as for genotype distribution of angiotensin converting enzyme (ACE) I/D variant. Based on these observations, the ACE I/D variant D/D genotypes implicate a possible risk in the FMF-related amyloidosis among Turkish population. PMID: 29891744
- Angiotensin-converting enzyme insertion/deletion gene polymorphism is associated with prostate cancer susceptibility. PMID: 29970692
- This study aimed to investigate the relationship between estimated training status (TS), blood pressure and angiotensin-converting enzyme (ACE) activity in elderly people classified as low or high risk to develop hypertension according to genetic profile. PMID: 29923443
- This study shows that ACE gene polymorphism, particularly the D allele, is associated with worse functional outcome of ischaemic stroke patients. PMID: 29199539
- ACE gene polymorphisms were not associated with the development of preeclampsia in South African Black women. PMID: 29523271
- summary of current knowledge about circulating ACE elevation in patients with granulomatous and non-granulomatous diseases. PMID: 29928904
- This study found that patients with the DD genotype reduced the exogenous EPO requirement as compared to the II genotype. Further, D allele frequency was higher in patients with diabetic nephropathy as compared to I allele which implies that D allele is an independent risk factor for progression to CKD. PMID: 28457029
- Prevalence has been found of ACTN3 R577X and of ACE insertion / deletion gene polymorphisms in national and amateur Turkish athletes. PMID: 29729690
- The ACE and AGT gene polymorphisms are not associated with the progress of diabetes developing into retinopathy in Chinese patients with type 2 diabetes. PMID: 29378484
- Review/Meta-analysis: ACE I/D polymorphism may be a genetic molecular marker to predict systemic lupus erythematosus but not lupus nephritis. PMID: 29205894
- Association of insertion/deletion (I/D) polymorphism at angiotensin-converting enzyme gene (ACE) with depression in Chinese adolescents experiencing the 2008 Wenchuan earthquake. PMID: 28982269
- The ACE (I/D) gene polymorphism do not seem to have a significant effect on the development of clinical properties or cardiovascular comordities of acromegalic patients. PMID: 28712073
- polymorphisms in the eNOS "A/A" (homozygous mutant) and ACE "I/D" genotypes might contribute to the increased risk of NSCLC in the South Indian population. PMID: 27328622
- The study attempts to understand the distribution and extent of association of ACE I/D gene polymorphism with cardiometabolic risk factors among Bhils from rural and urban settings. PMID: 29435690
- Data suggest that the insertion/deletion (I/D) ACE (angiotensin converting enzyme) gene polymorphism may be associated with MI occurrence among younger patients. PMID: 29268798
- The analysis of genotype coexistence revealed a higher incidence of the combination of the ACE II and the PAI-1 4G/4G genotypes in the control group (10.0 vs.5.9% in control group; p = 0.17). CONCLUSIONS: The obtained results suggest no apparent association between the ACE I/D, PAI-1 4G/5G polymorphisms and increased RM susceptibility in the analyzed Polish population. PMID: 27321098
- An involvement of the ACE polymorphism in element imbalances in hypertension PMID: 28303511
- Concomitant presence of non-functional variant in ACTN3 gene decreased this beneficiary effect of ACE mutation on SBPR3. PMID: 29269700
- There were significant differences in sarcopenic obesity according to ACE I/D genotype, Women who were ACE DD presented lower risk of sarcopenic obesity than those in the ACE II and ACE ID groups PMID: 29130707
- Patients with Alzheimer's disease who were homozygous for angiotensin-converting enzyme (ACE) Insertion allele presented with a more rapid AD deterioration than did those who had other ACE genotypes, particularly those patients without hypertension. PMID: 27862810
- The ACE D allele may be predictive in individuals who may be at risk of developing CAD. Further investigations of these polymorphisms and their possible synergisms with traditional risk factors for CAD could help to ascertain better predictability for CAD susceptibility. PMID: 27895197
- ACE DD genotype and overall frequency of D allele is significantly higher in patients with PPCM. Also, the presence of DD genotype is associated with worse systolic performance indices measured echocardiographically. PMID: 29455790
- There was an independent association of the angiotensin-converting enzyme polymorphism with central and ambulatory blood pressure in Chinese patients with Hypertension. PMID: 28834200
- expression not increased in the maternal vascular endothelium in subjects with preeclampsia compared with normal pregnant controls PMID: 28878298
- DD genotype and D allele of ACE gene I/D polymorphism might increase the risk of lymph node metastasis in colorectal cancer patients. PMID: 29032382
- The results suggest that ACE I/D polymorphism, high ACE activity, body mass index and oxidative damage may play key roles in the pathogenesis of preeclampsia in the Mexican population. PMID: 29153683
- SNPs in folate pathway genes MTHFR/ MTR/ACE and hyperhomocysteinemia have roles in risk of coronary artery disease. PMID: 28514598
- ACE I alleles are associated with dementia risk. PMID: 28657841
- Data indicate it is unlikely that ACE II genotype provides an advantage in endurance running. PMID: 29298672
- This study concludes that DD genotype is strongly associated with higher SBP in hypertensive patients. PMID: 29058472
- ACE binds to lysozyme and bilirubin, which regulate its conformation and shedding PMID: 27734897
- The presence of the ACE I-allele was associated with increased aerobic functional capacity after the aerobic interval training program. PMID: 29846435
- Study showed that dietary weight loss-induced changes in angiotensin-converting enzyme activity, free fatty acids and RBP4 independently contribute to weight regain prediction. PMID: 29122953
- Among the four haplotypes composed by ACE gene A2350G and I/D, haplotype G-D reached the statistical significance in two groups, and exhibited to be a risk factor for the development of EH, whose P < 0.001 and OR 95%CI = 1.639(1.435-1.872), while the other haplotypes were the protective factors and decreased the susceptibility to EH(P < 0.05). PMID: 29172745
- The serum ACE level could be a novel noninvasive, easy, accurate, and inexpensive marker of significant fibrosis stage in patients with chronic hepatitis B. PMID: 29085215
- ACE SNPs were not associated with bone density among lead workers. PMID: 29028685
- Study showed the association between rs4343 and susceptibility to migraine in a case-control population. PMID: 28626926
- Studied interleukin-1 receptor antagonist (IL-1Ra) and angiotensin-converting enzyme (ACE) I/D polymorphisms with regards to the susceptibility of patients to carpal tunnel syndrome. PMID: 28370589
- no correlation was found between the ACE and MTHFR polymorphisms in the development of T2DM. PMID: 29694640
- The ACE Ins/Del polymorphism was associated with body composition. Ins/Ins individuals had higher phase angle (PhA) and body cellular mass index (BCMI) values. Ins/Ins individuals displayed higher PhA and BCMI values only if norm-hydrated, while they showed values similar to Del carriers if dehydrated. PMID: 28315876
- The DD genotype for ACE was independently associated (b = -0.44, P = 0.007) with Alzheimer's disease patients in the island of IKARIA, Greece. PMID: 28379521
- The ACE I/D polymorphism (rs4340) may contribute to the genetic susceptibility of community-acquired pneumonia (CAP) in Egyptian children. The ACE D allele and DD genotype were associated with higher serum ACE levels among studied CAP patients. PMID: 29028160
- ACE indel polymorphism is a risk factor for allergic rhinitis. (Meta-analysis) PMID: 28886328
- the ACE DD genotype may increase the risk of renal scar in children with vesicoureteral reflex [meta-analysis] PMID: 27506878
- The AA and GA genotypes of MTHFD1 G1958A, TT and GT genotypes of eNOS G894T and the AA and GA genotypes of ACE A2350G are risk factors for congenital heart defects. PMID: 28865601
- The ACE D allele in aMCI patients may increase the risk of cognitive impairment. A high serum ACE level possibly plays an important role in the incidence of aMCI. PMID: 28870562
顯示更多
收起更多
-
相關疾病:Ischemic stroke (ISCHSTR); Renal tubular dysgenesis (RTD); Microvascular complications of diabetes 3 (MVCD3); Intracerebral hemorrhage (ICH)
-
亞細胞定位:[Angiotensin-converting enzyme, soluble form]: Secreted.; Cell membrane; Single-pass type I membrane protein. Cytoplasm.
-
蛋白家族:Peptidase M2 family
-
組織特異性:Ubiquitously expressed, with highest levels in lung, kidney, heart, gastrointestinal system and prostate. Isoform Testis-specific is expressed in spermatocytes and adult testis.
-
數據庫鏈接:
Most popular with customers
-
-
YWHAB Recombinant Monoclonal Antibody
Applications: ELISA, WB, IHC, IF, FC
Species Reactivity: Human, Mouse, Rat
-
Phospho-YAP1 (S127) Recombinant Monoclonal Antibody
Applications: ELISA, WB, IHC
Species Reactivity: Human
-
-
-
-
-